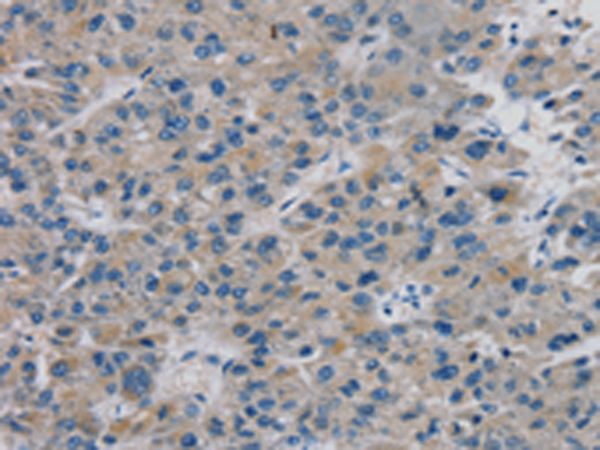

|
Background: |
This genes codes for a member of an evolutionarily conserved family of transcription factors that plays a crucial role in embryonic development. The family is characterized by the presence of the DNA-binding T-box domain and is divided into five sub-families based on sequence conservation in this domain. The encoded protein belongs to the vertebrate specific Tbx1 sub-family. The protein acts as a transcriptional repressor by antagonizing transcriptional activators in the T-box family. The protein forms homo- or heterodimers with other transcription factors of the T-box family or other transcription factors. |
|
Applications: |
ELISA, IHC |
|
Name of antibody: |
TBX18 |
|
Immunogen: |
Fusion protein of human TBX18 |
|
Full name: |
T-box 18 |
|
SwissProt: |
O95935 |
|
ELISA Recommended dilution: |
1000-2000 |
|
IHC positive control: |
Human liver cancer |
|
IHC Recommend dilution: |
10-50 |
購物車
購物車 幫助
幫助
 021-54845833/15800441009
021-54845833/15800441009
